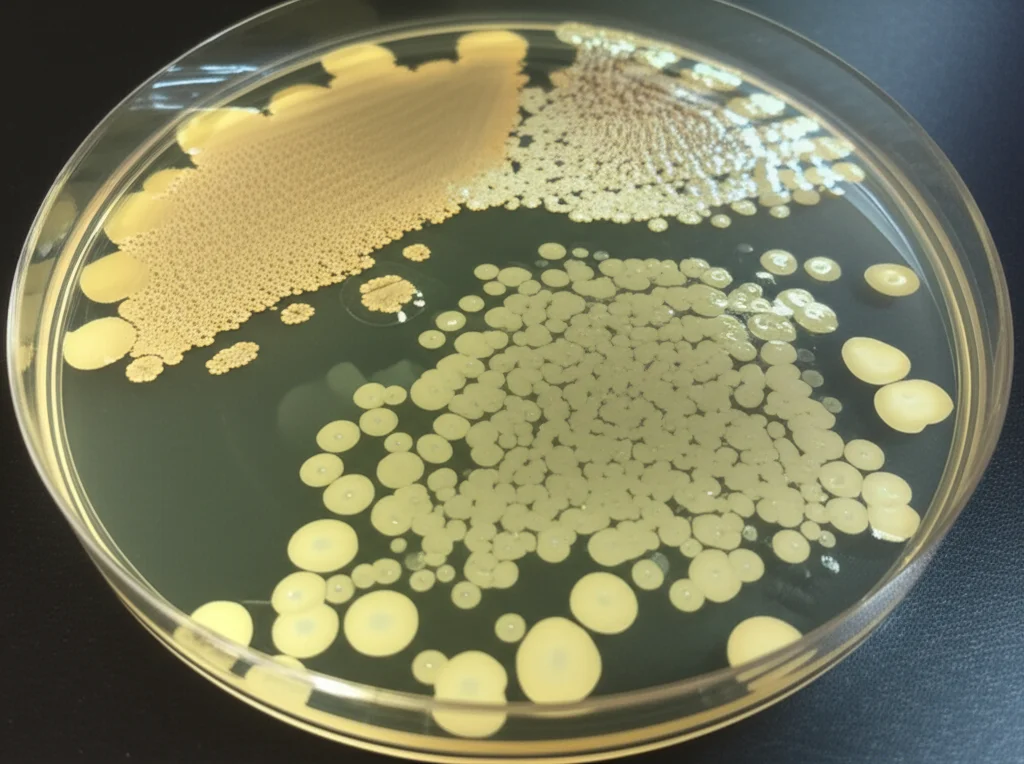
Primo piano di una piastra di Petri con colonie batteriche e zone di inibizione chiare attorno a pozzetti contenenti campioni trattati. Obiettivo macro 60mm, illuminazione da laboratorio precisa, alta definizione.

LDH Super-Potenziati: La Soluzione Sostenibile per Acque Libere dall’Antibiotico Levofloxacina!
Ciao a tutti! Oggi voglio parlarvi di un problema serio ma affascinante dal punto di vista scientifico: l’inquinamento delle nostre acque da farmaci, in particolare dagli antibiotici. Immaginate, sostanze create per curarci che, una volta disperse nell’ambiente, diventano una minaccia persistente. La levofloxacina, un antibiotico molto comune, è uno dei “sorvegliati speciali” perché finisce spesso nelle acque reflue e può contribuire a un fenomeno ancora più preoccupante: l’antibiotico-resistenza. Un bel grattacapo, vero?
I tradizionali impianti di trattamento delle acque faticano a eliminare completamente queste molecole complesse. Ecco perché noi ricercatori siamo sempre alla caccia di soluzioni innovative e sostenibili. E qui entra in gioco la nostra scoperta!
Idrossidi Doppi Lamellari (LDH): I Nostri Eroi a Strati
Abbiamo puntato su una classe di materiali chiamati Idrossidi Doppi Lamellari (LDH). Pensateli come minuscole “lasagne” a livello molecolare, con strati carichi positivamente e ioni negativi nello spazio intermedio. Questa struttura unica li rende fantastici “acchiappa-molecole”, specialmente per inquinanti come gli antibiotici.
Nello specifico, abbiamo lavorato con un LDH a base di Zinco (Zn), Cobalto (Co) e Ferro (Fe). Perché questa combinazione? Perché questi metalli lavorano in sinergia: lo Zinco dà stabilità, il Cobalto aggiunge proprietà redox utili e il Ferro migliora ulteriormente l’efficienza di cattura. Sembrava già promettente, ma volevamo di più!
L’Innovazione: Potenziare gli LDH con Rame e Cianoguanidina
La vera svolta è arrivata modificando il nostro LDH Zn-Co-Fe. Abbiamo introdotto un complesso a base di Rame (Cu) e Cianoguanidina. Questa aggiunta non è casuale: la Cu-Cianoguanidina agisce come un agente “chelante”, una sorta di pinza molecolare che aumenta la capacità e la selettività dell’LDH nell’afferrare proprio la levofloxacina. Il risultato? Un materiale ibrido, che abbiamo chiamato Cu-Cianoguanidina-ZnCoFe/LDH, ancora più performante.
Abbiamo sintetizzato entrambi i materiali (l’LDH base e quello modificato) con un metodo chiamato co-precipitazione – una tecnica relativamente semplice ed economica. Poi, li abbiamo “interrogati” con una batteria di analisi avanzate (FTIR, XRD, SEM, TEM, BET, XPS…) per capirne la struttura, la morfologia e la composizione chimica fin nei minimi dettagli. Volevamo essere sicuri che i nostri materiali fossero esattamente come li avevamo progettati. Le analisi hanno confermato la struttura lamellare tipica degli LDH e l’effettiva incorporazione del complesso Cu-Cianoguanidina.

Risultati Sorprendenti: Catturare la Levofloxacina
E ora, la parte più emozionante: i test di rimozione! Abbiamo messo alla prova i nostri materiali in diverse condizioni, variando il pH dell’acqua, la quantità di materiale usato (la “dose”) e il tempo di contatto.
Il nostro LDH modificato, Cu-Cianoguanidina-ZnCoFe/LDH, si è rivelato una vera star: è riuscito a rimuovere ben il 90% della levofloxacina presente nell’acqua a pH 9! Un risultato eccellente. Ma come ci riesce? Abbiamo scoperto che entrano in gioco diversi meccanismi:
- Interazioni elettrostatiche: Attrazione tra le cariche opposte del materiale e della molecola di antibiotico.
- Legami a idrogeno: Un tipo speciale di “ponte” chimico.
- Interazioni π-π stacking: Un’attrazione tra gli anelli aromatici presenti sia nell’antibiotico che nel nostro materiale modificato.
- Complessazione superficiale: I metalli (soprattutto Fe³⁺ e Cu²⁺) legano direttamente gruppi funzionali della levofloxacina.
- Scambio ionico: L’antibiotico (in forma anionica) prende il posto di altri ioni presenti tra gli strati dell’LDH.
Insomma, un lavoro di squadra a livello molecolare!
Abbiamo anche studiato la cinetica (quanto velocemente avviene la rimozione) e le isoterme (quanta levofloxacina può catturare il materiale al massimo). I modelli cinetici indicano un mix di meccanismi fisici e chimici, mentre il modello di isoterma di Langmuir ci ha rivelato una capacità massima di adsorbimento (Qmax) impressionante per l’LDH modificato: ben 390 mg di levofloxacina per grammo di materiale!
Non Solo Efficace, Ma Anche Riutilizzabile!
Uno degli aspetti più importanti per una soluzione sostenibile è la possibilità di riutilizzare il materiale. Abbiamo testato la rigenerazione del nostro Cu-Cianoguanidina-ZnCoFe/LDH usando una semplice soluzione di idrossido di sodio (NaOH). I risultati? Fantastici! Dopo quattro cicli di adsorbimento e rigenerazione, il materiale manteneva ancora il 93,9% della sua capacità iniziale. Questo significa meno sprechi, costi operativi ridotti e un impatto ambientale minore. La modifica con Cu-Cianoguanidina non solo ha migliorato l’efficienza, ma ha anche reso la rigenerazione più efficace rispetto all’LDH non modificato (che comunque si difendeva bene con l’82%).

Un Materiale con una Doppia Anima: Antibatterico Anche Senza Antibiotico
Qui arriva un’altra sorpresa affascinante. Ci siamo chiesti: cosa succede all’attività antibatterica dell’acqua dopo il trattamento? E il materiale stesso, ha qualche proprietà biologica?
Abbiamo condotto test di citotossicità su cellule umane (linea HEK293) per verificare la sicurezza dei materiali. A basse concentrazioni, entrambi gli LDH si sono dimostrati biocompatibili, anche se l’LDH modificato ha mostrato una leggera tossicità in più ad alte dosi, probabilmente dovuta al rame.
Poi, abbiamo usato il classico metodo della diffusione su agar per vedere se l’acqua trattata avesse ancora attività antibatterica contro batteri comuni come Escherichia coli e Staphylococcus aureus (MRSA, un ceppo resistente). Come previsto, l’acqua non trattata (contenente levofloxacina) inibiva la crescita batterica. L’acqua trattata con i nostri LDH, invece, non mostrava più questa inibizione, confermando l’efficace rimozione dell’antibiotico.
Ma la cosa più interessante è che il materiale Cu-Cianoguanidina-ZnCoFe/LDH, anche dopo aver rimosso la levofloxacina, ha mostrato una propria attività antibatterica e anti-biofilm! Il complesso Cu-Cianoguanidina sembra disturbare la membrana cellulare dei batteri, e il rame è noto per generare specie reattive dell’ossigeno (ROS) che danneggiano le cellule batteriche. Quindi, il nostro materiale non solo pulisce l’acqua dall’antibiotico (riducendo il rischio di resistenza), ma aggiunge anche un effetto battericida diretto!
Dalla Provetta all’Occhio: Un Test In Vivo Promettente
Visto il potenziale antibatterico, abbiamo voluto spingerci oltre. La levofloxacina è usata anche in colliri per infezioni oculari come la cheratite batterica. Abbiamo quindi testato i nostri materiali in un modello animale (ratti con cheratite indotta da Staphylococcus aureus).
Abbiamo confrontato diversi trattamenti: controllo infetto non trattato, trattamento con levofloxacina prima della rimozione (usando i nostri LDH come “veicolo”), e trattamento *dopo* la rimozione della levofloxacina (per vedere l’effetto del solo LDH). Abbiamo anche testato diverse frequenze di somministrazione.
I risultati sono stati illuminanti. Come atteso, la levofloxacina era efficace. Ma, cosa notevole, il gruppo trattato con Cu-Cianoguanidina-ZnCoFe/LDH *dopo* la rimozione della levofloxacina ha mostrato un miglioramento significativo dell’infezione, anche con una somministrazione meno frequente (una volta al giorno invece di tre). L’analisi istologica delle cornee ha confermato che questo materiale aiutava a ridurre l’infiammazione e a preservare l’integrità del tessuto meglio del solo LDH base dopo la rimozione dell’antibiotico. Questo suggerisce che le proprietà antibatteriche intrinseche del nostro materiale modificato possono avere applicazioni terapeutiche dirette!

Costi, Limiti e Prospettive Future
Ovviamente, per un’applicazione reale, bisogna considerare i costi. Abbiamo stimato il costo di produzione del nostro Cu-Cianoguanidina-ZnCoFe/LDH a circa 0.94 USD per grammo, un valore che lo rende competitivo rispetto ad altri adsorbenti commerciali, specialmente considerando la sua alta efficienza e riutilizzabilità.
Siamo consapevoli che questi sono studi di laboratorio. Il prossimo passo sarà testare il materiale in condizioni più realistiche, su scala pilota, valutandone la stabilità a lungo termine e l’efficacia in acque reflue reali, che contengono un mix di inquinanti. Bisognerà anche approfondire l’impatto ambientale a lungo termine, assicurandosi che non ci siano rilasci indesiderati di metalli.
In Conclusione: Una Speranza Concreta
Il nostro lavoro dimostra che il Cu-Cianoguanidina-ZnCoFe/LDH è un candidato eccezionale per affrontare due sfide globali: l’inquinamento da farmaci e l’antibiotico-resistenza. Abbiamo sviluppato un materiale che non solo rimuove efficacemente la levofloxacina dalle acque (con un’efficienza del 90%), ma è anche robusto, riutilizzabile (oltre il 93% di capacità dopo 4 cicli) e possiede proprietà antibatteriche intrinseche.
Questa “doppia azione” – pulire l’acqua e combattere i batteri – lo rende particolarmente promettente. Immaginate di poter integrare questi materiali negli impianti di trattamento esistenti, offrendo una soluzione più verde ed efficace. La strada verso l’applicazione su larga scala richiede ancora lavoro, ma i risultati sono incredibilmente incoraggianti. Stiamo contribuendo a sviluppare tecnologie per un futuro con acque più pulite e un minor rischio di resistenze batteriche. E questo, lasciatemelo dire, è davvero appassionante!
Fonte: Springer







